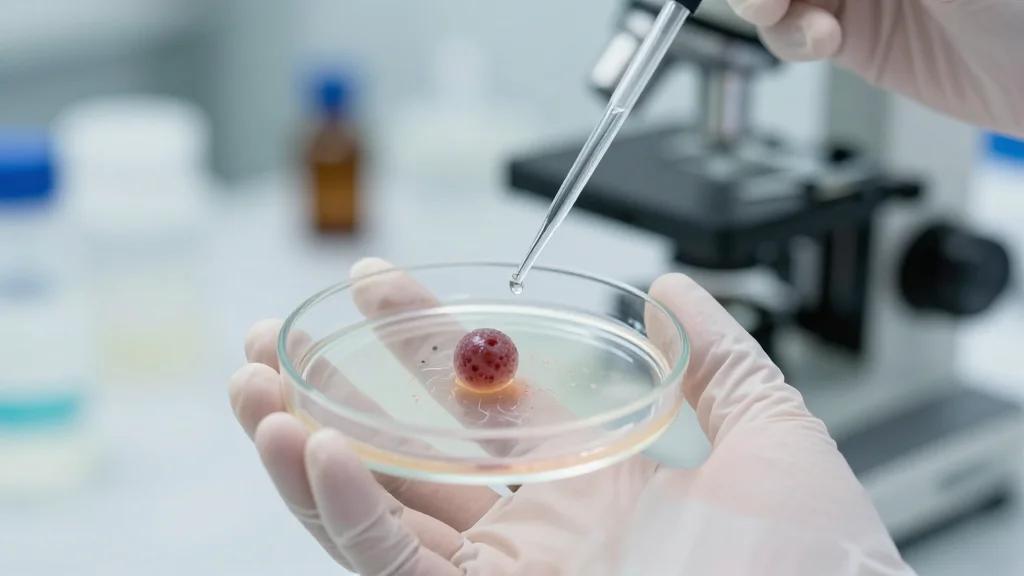
Pancreatic Cancer Cells Sense ECM to Switch Between Growth and Autophagy

What the FDA’s Priority Voucher Decision Means for Psychedelic Drug Development
The FDA’s Commissioner’s National Priority Review Voucher (CNPV) pilot compresses review timelines to one‑to‑two months for qualifying drugs, but its criteria favor applications with mature data packages. Compass Pathways’ synthetic psilocybin (COMP360) was listed as eligible yet did not receive a voucher, highlighting the program’s bias toward established products rather than first‑in‑class psychedelics. The article stresses that expedited pathways do not lower safety or efficacy standards and that psychedelics face added hurdles such as REMS requirements and DEA rescheduling. Investors and developers must treat vouchers as optional accelerants, not guaranteed routes to market.

Before AGBT Kicks Off, Ultima Unveils the UG 200
Ultima Genomics announced the UG 200 series, a second‑generation sequencing platform that includes a single‑wafer UG 200 and a dual‑wafer UG 200 Ultra. Both instruments are half the size of the UG 100, cost less (starting at $850,000), and deliver...

How to Avoid a Fall by Balancing Cost and Performance in Drug Discovery
Balancing cost and performance in drug discovery requires a hybrid engineering‑led approach that combines on‑premise HPC with scalable cloud resources. Uncontrolled cloud scaling can drive unpredictable expenses, while pure on‑premise systems demand high upfront capital and maintenance. By implementing disciplined...

Hormone-Regulated Immune Cells Implicated in Longer Lasting Pain in Women
Researchers at Michigan State University discovered that hormone‑regulated monocytes producing interleukin‑10 (IL‑10) drive faster pain resolution in males. In mouse models, testosterone‑dependent IL‑10+ monocytes cleared inflammatory pain more quickly, while females exhibited fewer of these cells and prolonged pain. Human...

Electronic Mesh Spurs Islet Cell Maturation, Could Aid Diabetes Care
Researchers at the University of Pennsylvania and Harvard have created an ultrathin, flexible electronic mesh that can be implanted into developing pancreatic tissue. The mesh delivers a 24‑hour rhythmic electrical pulse, coaxing stem‑cell‑derived islet cells toward functional maturity and synchronized...

Vaccine Protects Against Multiple Respiratory Viruses, Bacteria, and Allergens in Mice
Stanford researchers have created an intranasal vaccine that elicits a combined innate‑adaptive response, providing broad lung protection in mice. The formulation, containing TLR agonists and a harmless antigen, shielded animals for at least three months against SARS‑CoV‑2, other coronaviruses, two...

Lower Glucose by Living High
Researchers at Gladstone Institutes discovered that red blood cells (RBCs) act as a primary glucose sink during hypoxia, explaining why people living at high altitude have lower blood sugar. PET/CT scans showed 70% of the extra glucose clearance in hypoxic...

Lonza Boosts Advanced Synthesis Capabilities for Bioconjugates
Lonza has expanded its advanced synthesis portfolio to provide end‑to‑end support for antibody‑drug conjugates (ADCs) and other bioconjugates. The company fully integrated the Synaffix‑derived ADC platform—including GlycoConnect® conjugation, HydraSpace® spacers and toxSYN® linker payloads—into its services. A new dual‑payload ADC...

On Its 15th Anniversary, Foresite Capital Looks Ahead
Foresite Capital marked its 15th anniversary by projecting a resurgence in biopharma venture capital, anticipating a year‑over‑year rise in financings and IPOs starting in 2026. The firm highlighted a surge to $149 billion in biopharma VC dollars in 2025 and a...

Cancer Immunotherapy Improved Using Targeted Stress Protein
Researchers at NYU Langone Health identified the integrated stress response protein lipocalin 2 (LCN2) as a key mediator that lets lung and pancreatic tumors evade immune attack. In mouse models, antibodies that block LCN2 restored T‑cell infiltration, slowed tumor growth, and...

SPT Labtech, BellBrook Labs Automate Screening for VPS4B ATPase Inhibitors for Cancer Drug Discovery
SPT Labtech and BellBrook Labs announced a joint effort to automate a high‑throughput, cell‑based assay for VPS4B ATPase inhibitors, pairing BellBrook’s Transcreener® ADP2 fluorescence‑polarization assay with SPT’s dragonfly® liquid‑handling system. The miniaturized platform operates in 384‑ and 1536‑well formats and...

ArgenTag, PacBio Partner on Long-Read Single-Cell Transcriptomics
ArgenTag, a Buenos Aires‑based startup, has entered PacBio’s Compatible Partner Program, confirming that its Single‑Cell RNA Library Kit works with PacBio’s Kinnex RNA kits for long‑read isoform sequencing. The partnership eliminates the need for expensive cell‑partitioning instruments by using ArgenTag’s...
Pancreatic Cancer Cells Sense ECM to Switch Between Growth and Autophagy
Researchers at NYU Langone Health discovered that pancreatic ductal adenocarcinoma cells sense extracellular matrix (ECM) components via the surface protein integrin α3, which determines whether they adopt a proliferative or autophagic state. Cells anchored to laminin‑rich ECM keep autophagy low and...

Turning Microalgae-Derived Extracellular Vesicles Into a Next-Generation Drug Delivery Platform
Paris‑based AGS Therapeutics signed a strategic agreement with INITS SMO, a GMP‑qualified shared manufacturing organization, to transition its microalgae‑derived extracellular vesicle (MEV) platform to full GMP compliance. The partnership allows AGS to run its proprietary MEV manufacturing, loading, and analytics...

Prima Mente Unlocks Early-Stage Alzheimer’s Diagnostics with Epigenome Model
AI biology firm Prima Mente has launched Pleiades, a 7‑billion‑parameter epigenetic foundation model that reads DNA methylation in cell‑free DNA to diagnose early‑stage Alzheimer’s and Parkinson’s. In real‑world cohorts the model achieved 89% detection accuracy, rising to 97% when combined...

ML‑Predicted Insulin Resistance Identified as Risk Factor in 12 Cancers
Researchers at the University of Tokyo applied a machine‑learning tool, AI‑IR, to estimate insulin resistance in half a million UK Biobank participants. The analysis revealed insulin resistance as a significant risk factor for twelve distinct cancer types, providing the first...

Systematic Discovery of Molecular Glues Targets Protein Degradation in Leukemia
Researchers at the AITHYRA Institute introduced a high‑throughput chemical diversification platform that systematically creates molecular‑glue candidates and screens them directly in living cells. Applying the workflow to the leukemia‑associated protein ENL, they identified a small molecule that selectively induces ENL...

Fujifilm Biotechnologies Opens Largest Single-Use CDMO Facility in the UK
Fujifilm Biotechnologies has opened an expanded UK site in Teesside, marking the launch of the country’s largest single‑use biopharmaceutical CDMO facility. The £400 million investment adds 2,000 L and 5,000 L single‑use bioreactors, delivering up to 19,000 L of small‑ and mid‑scale antibody manufacturing...

Pod-Based, On-Demand Media and Buffer Manufacturing System
Nucleus Biologics introduced the Krakatoa K500, the first bioreactor‑scale, pod‑based system that manufactures sterile cell‑culture media and buffers on‑demand at point‑of‑use. The solution combines pre‑filled powder pods, a closed single‑use workflow and automated mixing, delivering up to 500 L in under three...

Women in Science, Robotics, Automation, SLAS, and Lilly Updates
The GEN podcast highlighted Women in Science Day, noting the term “scientist” was originally coined for a woman, and featured Medra CEO Michelle Lee discussing the integration of AI‑driven robotics into biological research. It also covered automation advances presented at...

Antigen Orientation Boosts HPV Cancer SNA Vaccine, Slows Tumors in Models
Northwestern researchers engineered a spherical nucleic acid (SNA) vaccine in which the HPV16 E7 peptide is displayed at the nanoparticle surface via its N‑terminus. This N‑terminal orientation (N‑HSNA) generated up to eight‑fold higher interferon‑γ secretion and 2.5‑fold greater cytotoxicity than...

Terray’s AI Model Accelerates Drug Potency Prediction, Pose Not Needed
Terray Therapeutics unveiled TerraBind, an AI model that predicts small‑molecule potency without generating a binding pose. The model delivers roughly 20% higher accuracy and a 26‑fold efficiency boost versus the open‑source Boltz‑2 benchmark. By eliminating the computationally intensive pose step,...

Robots on the Red Line: A Video Update From SLAS 2026
The Society for Laboratory Automation and Screening (SLAS) 2026 conference in Boston highlighted a surge in laboratory robotics and AI-driven automation. Speakers showcased new modular robot platforms and discussed scaling high‑throughput omics workflows. The keynote underscored how intelligent automation can...

Anti-Epileptic Drug May Prevent Early Plaque Formation in Alzheimer’s Disease
Scientists at Northwestern University identified that the toxic amyloid‑beta 42 peptide accumulates inside neuronal synaptic vesicles and that the FDA‑approved anti‑epileptic drug levetiracetam can halt this process. By binding to the SV2A protein, levetiracetam alters APP trafficking, keeping the precursor...

Streamlining Research Antibody and Reagent Selection
CiteAb unveiled the Explore Platform, combining its long‑standing reagent search engine with a new image‑search capability. The platform draws on a database of more than 16 million research tools cited in over 40 million publications, spanning antibodies, proteins, models and kits. Its...

Immunotherapy Blocking Microglial FcγR Prevents Neuron Loss in Parkinson’s Disease
Researchers identified that microglia in Parkinson’s disease express elevated low‑affinity Fcγ receptors (CD16/CD32), which mistakenly target healthy dopaminergic neurons for phagocytosis. Using post‑mortem tissue, mouse models, and cell cultures, they demonstrated that blocking these receptors with neutralizing antibodies—or inhibiting downstream...

Genentech, SanegeneBio Launch Up-to-$1.7B RNAi Collaboration
Genentech, part of Roche, signed a global licensing deal with Chinese biotech SanegeneBio to develop an undisclosed RNA interference program. The agreement includes a $200 million upfront payment and up to $1.5 billion in milestone‑linked payments, plus royalties. SanegeneBio retains early‑stage development...

Mutation Map Indicates How Alterations in Key Cancer Gene Influence Tumor Growth
An international team led by the University of Edinburgh created a comprehensive functional map of 342 possible missense mutations in the CTNNB1 hotspot, assigning activity scores to over 80% of cancer‑observed variants. Using mouse stem cells and genome‑editing, they measured...

Sinorda and WuXi Partner on Bispecific Antibody Development and Manufacturing
Sinorda Biomedicine has teamed with WuXi Biologics to develop and manufacture SND006, a bispecific antibody aimed at treating inflammatory bowel disease and other autoimmune conditions. The partnership leverages WuXi’s extensive biologics expertise to accelerate preclinical pharmacology, clinical‑supply manufacturing, and IND...

Gut Microbes Shape Cancer Growth and Immunity Through Asparagine Metabolism
A new study published in Cell Host & Microbe shows that gut bacteria can control cancer progression by modulating asparagine availability. The enzyme‑encoding bo‑ansB gene in Bacteroides ovatus depletes intestinal asparagine, limiting its delivery to tumors and impairing CD8+ T‑cell...

Ex-CEO Behind Bars, 10x’s Clinical Ambitions, Pharma’s AI Gambit
The former CytoDyn chief executive was sentenced to 30 months in prison after convictions for securities fraud, wire fraud and insider trading. Meanwhile, major pharmaceutical companies are accelerating AI adoption, signing multi‑billion‑dollar deals with platform providers such as Nvidia and...

Mosaic’s Nanoneedle Granted Advanced Manufacturing Technology Designation for Gene Therapy Products
The FDA’s Center for Biologics Evaluation and Research granted NanoMosaic an Advanced Manufacturing Technology (AMT) designation for its Nanoneedle platform, which multiplexes vector genome and capsid titer testing in AAV gene‑therapy production. The designation confirms the technology’s ability to streamline...

DNA-Protein Crosslinks Drive Inflammation Linked to Early Aging
Researchers have shown that unrepaired DNA‑protein crosslinks (DPCs) provoke chronic inflammation via the cGAS‑STING pathway, leading to premature aging and embryonic lethality in mice. The study identifies the SPRTN protease as the key enzyme that resolves DPCs during replication and...

Hippocampal Replay Persists but Loses Structure in Alzheimer’s Model
Researchers at UCL found that hippocampal replay persists but loses structural coherence in an Alzheimer’s mouse model. While the frequency of replay events remained normal, the ordered activation of place cells was disrupted, leading to weakened co‑firing patterns. This neural...

Immunotherapy Reduces Plaque in Mouse Arteries, Suggesting Coronary Disease Intervention
Researchers at Washington University and Amgen created a bispecific T‑cell engager (BiTE) that selectively eliminates fibroblast activation protein (FAP)‑positive modulated smooth‑muscle cells in mouse atherosclerosis models. The treatment cut plaque burden, lowered inflammation, and enhanced plaque stability, suggesting a new...

Barbados Government and BioMed X Partner to Improve AI-Based Early Diabetic Kidney Disease Modeling
BioMed X, a German pharma innovation hub, has teamed up with the Barbados government and the EU’s PharmaNext programme to launch an AI‑enabled research initiative targeting early diabetic kidney disease in the island’s type‑2 diabetes population. The project will combine...

Brain Organoids Map How Distinct Autism Mutations Converge in Early Development
Researchers used human induced pluripotent stem cell‑derived brain organoids to map the impact of eight autism‑linked genetic mutations. RNA‑seq across four developmental stages showed that early distinct molecular signatures gradually converge on shared pathways governing neuronal maturation and synapse formation....

How IFN Signaling Tunes Macrophage Mitochondria in Inflammation Resolution
A preclinical study at Spain’s CNIC revealed that type‑I interferon (IFN‑I) reprograms macrophage mitochondria through the ISG15 protein. IFN‑I binding to IFNAR lowers mitochondrial membrane potential while paradoxically increasing ATP output, prompting mitochondrial fission. These metabolic shifts boost efferocytosis, accelerating...

Nautilus, Weill Cornell Team Up to Apply Single Molecule Proteomics Tech to Parkinson’s
Nautilus and Weill Cornell Medicine‑Qatar have secured $1.6 million from the Michael J. Fox Foundation to develop a single‑molecule proteomics assay for alpha‑synuclein proteoforms in Parkinson’s disease. The collaboration merges Hilal Lashuel’s expertise in alpha‑synuclein post‑translational modifications with Nautilus’s Iterative Mapping...

Glucose Monitoring with Novel Reusable Sensor
Hamilton has launched the GlucoSense reusable sensor, a compact inline probe that provides real‑time glucose monitoring for mammalian cell cultures. The device uses infrared spectrometry and integrates directly with its transmitter, eliminating the need for an external spectrometer or lengthy...

Permittivity Provides an In-Line Cell Health Early-Warning System
Merck scientists demonstrated that dielectric spectroscopy, measured as permittivity, can serve as an in‑line early‑warning system for apoptosis in CHO cell cultures. By analyzing Cole‑Cole model parameters—critical frequency (fc) and delta epsilon (Δε)—they captured stress‑induced shifts before conventional viability assays...

PH Denaturation of dsRNA for mRNA Purification
Scientists at Sartorius BIA Separations and Johannes Gutenberg University have introduced a low‑pH denaturation step that melts double‑stranded RNA (dsRNA) impurities in mRNA streams within seconds. By adjusting the pH to 3.5 or lower, dsRNA levels fall below 0.1% while...

Rethinking Vaccine Production Platforms for Future Pandemics
New analysis highlights yeast-based protein expression as a promising vaccine platform for future pandemics. While mRNA and viral vector technologies enabled rapid COVID‑19 vaccine rollout, their high cost, manufacturing complexity, and cold‑chain requirements limited access in low‑income regions. Yeast systems...

Function of Cell Surface glycoRNAs Identified
Researchers led by Ryan Flynn have identified the cellular pathway that places glycoRNAs on the cell surface and demonstrated that these RNA‑glycan hybrids bind and inhibit VEGF‑A signaling. Genetic screens linked heparan sulfate to glycoRNA presentation, and loss of glycoRNAs...

Malabsorption Detected by Glowing Bacterial Biosensors in Mice
University of British Columbia researchers engineered the native gut bacterium Bacteroides thetaiotaomicron to act as a continuous, noninvasive biosensor that glows brightly under normal conditions and dims when osmotic stress indicates malabsorption. Published in Cell, the study demonstrated in mice...

IXCells and Rosebud Biosciences Partner on Organoid-Based Rare Disease Models
iXCells Biotechnologies is integrating Rosebud Biosciences’ AI‑driven organoid platform with its iPSC‑based iPSCore system to deliver scalable, three‑dimensional human tissue models. The partnership combines iXCells’ modular stem‑cell production with Rosebud’s reproducible organoid generation and characterization capabilities. Together they aim to...

Lilly, Seamless Ink Up-to-$1.12B Hearing Loss Collaboration
Eli Lilly has signed a global research and licensing deal with German gene‑editing startup Seamless Therapeutics to develop hearing‑loss treatments using Seamless’s programmable recombinase platform. The agreement grants Lilly exclusive rights to engineered recombinases that can insert large DNA fragments...

Bacterial Biofilms Unexpectedly Found Inside Most Common Kidney Stones
Researchers have identified live bacteria and biofilms embedded within calcium oxalate kidney stones, the most common stone type, overturning the long‑standing belief that stones form solely through chemical and physical processes. The PNAS study used electron and fluorescence microscopy to...

How Brain May Deliberately Form Amyloids to Turn Experiences Into Memories
Stowers Institute researchers identified a J‑domain chaperone, dubbed Funes, that deliberately induces functional amyloid formation of the Orb2 protein in fruit‑fly neurons, enabling long‑term memory consolidation. Overexpressing Funes markedly improves 24‑hour odor‑reward recall, while disrupting its interaction with Orb2 eliminates...

HanchorBio and WuXi Biologics Form Fusion Protein Pipeline Partnership
HanchorBio and WuXi Biologics have signed a strategic collaboration to develop and manufacture multiple next‑generation fusion protein programs from HanchorBio’s Fc‑Based Designer Biologics platform. WuXi will provide end‑to‑end services including cell line creation, process and bioassay development, formulation, and GMP...